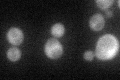
YPL015C
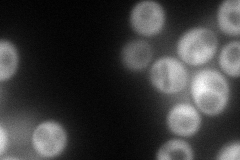
YPL015C
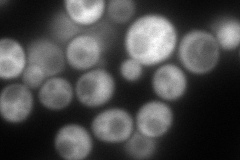
YPL015C
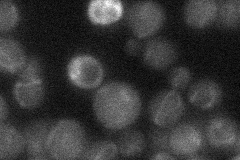
YPL015C
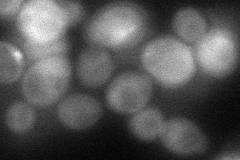
YPL015C
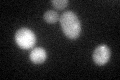
YPL015C
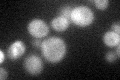
YPL015C

View description
Cytoplasmic member of the silencing information regulator 2 (Sir2) family of NAD(+)-dependent protein deacetylases; modulates nucleolar (rDNA) and telomeric silencing; possesses NAD(+)-dependent histone deacetylase activity in vitro
Localization:
Intensity:
Fold change:
Significance:
-
C’ GFP library in SD
cytosol41.67 -
N' NOP1pr-GFP in SD
cytosol137.987 -
N' TEF2pr-mCherry in SD
cytosol179.523 -
N' NATIVEpr-GFP in SD
below threshold17.7889 -
N' TEF2pr-VC and Cyto-VN in SD
cytosol62.9604 -
C’ GFP library in SD+DTT
cytosol30.210.72No -
C’ GFP library in SD+H2O2

cytosol44.061.05No -
C’ GFP library in Starvation Media
cytosol52.811.26No -
C’ GFP library on the background of Pup2-DaMP

cytosol -
C’ GFP library on the background of CCT mutant

cytosol42.16941.01194No
